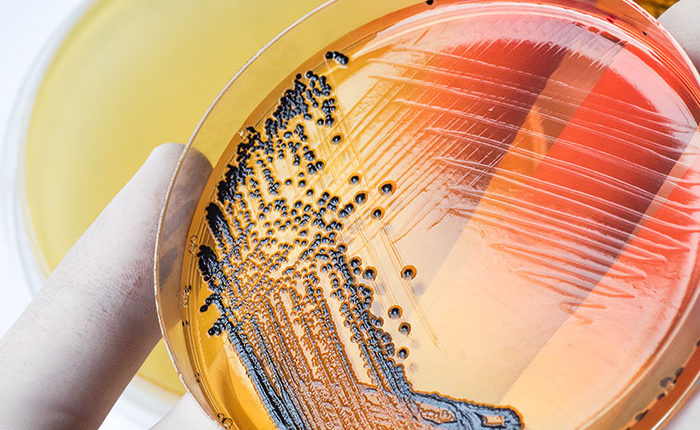

Ο ΕΦΕΤ ανακοινώνει ότι στο πλαίσιο εφαρμογής του άρθρου 4, του ν.2741/1999 (ΦΕΚ 199/Α/1999) και του Κανονισμού (ΕΕ) 2017/625, εκδόθηκε η υπ’ αριθμ. 127/24.04.2020 απόφαση του Διοικητικού Συμβουλίου του, με την οποία τίθεται σε ισχύ η διαδικασία ένταξης εργαστηρίων στο «Μητρώο Εργαστηρίων Επισήμου Ελέγχου Τροφίμων συνεργαζομένων με τον ΕΦΕΤ».
Ο ΕΦΕΤ ανακοινώνει ότι στο πλαίσιο εφαρμογής του άρθρου 4, του ν.2741/1999 (ΦΕΚ 199/Α/1999) και του Κανονισμού (ΕΕ) 2017/625, εκδόθηκε η υπ’ αριθμ. 127/24.04.2020 απόφαση του Διοικητικού Συμβουλίου του, με την οποία τίθεται σε ισχύ η διαδικασία ένταξης εργαστηρίων στο «Μητρώο Εργαστηρίων Επισήμου Ελέγχου Τροφίμων συνεργαζομένων με τον ΕΦΕΤ».
Σύμφωνα με την εν λόγω απόφαση, εργαστήρια του ιδιωτικού τομέα ή του δημοσίου τομέα που δεν έχουν συνεργαστεί προηγουμένως με τον ΕΦΕΤ, και δραστηριοποιούνται στο χώρο των τροφίμων ή/και υλικών και αντικειμένων που προορίζονται να έλθουν σε επαφή με τα τρόφιμα, δύνανται με αίτησή τους να καταχωριστούν στο «Μητρώο Εργαστηρίων Επισήμου Έλεγχου Τροφίμων συνεργαζομένων με τον ΕΦΕΤ».
Πληροφορίες σχετικά με τα κριτήρια επιλογής, τους όρους συνεργασίας με τον ΕΦΕΤ, τη διαδικασία ένταξης, καθώς και τα απαραίτητα έγγραφα και δικαιολογητικά βρίσκονται αναρτημένες στην ιστοσελίδα του ΕΦΕΤ στη διεύθυνση: http://www.efet.gr/index.php/el/enimerosi/anakoinoseis-ekdiloseis/anakoinoseis-cat/item/4934-diadikasia-entaksis-ergastirion-sto-mitroo-ergastirion-episimou-elegxou-trofimon-synergazomenon-me-ton-efet